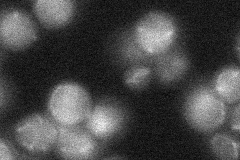

View description
Acetytransferase required for sister chromatid cohesion; modifies Smc3p at DNA replication forks during S-phase; modifies Mcd1p in response to double-strand DNA breaks during G2/M; acetylation of cohesin subunits antagonizes Rad61p
Localization:
Intensity:
Fold change:
Significance:
-
C’ GFP library in SD

nucleus16.7 -
N' NOP1pr-GFP in SD

nucleus41.2892 -
N' TEF2pr-mCherry in SD

nucleus34.8645 -
N' NATIVEpr-GFP in SD
below threshold19.1828 -
N' TEF2pr-VC and Cyto-VN in SD

below threshold26.3164 -
C’ GFP library in SD+DTT

nucleus19.311.15No -
C’ GFP library in SD+H2O2

nucleus19.261.15No -
C’ GFP library in Starvation Media

nucleus17.431.04No -
C’ GFP library on the background of Pup2-DaMP

nucleus -
C’ GFP library on the background of CCT mutant

nucleus18.43681.10349No
